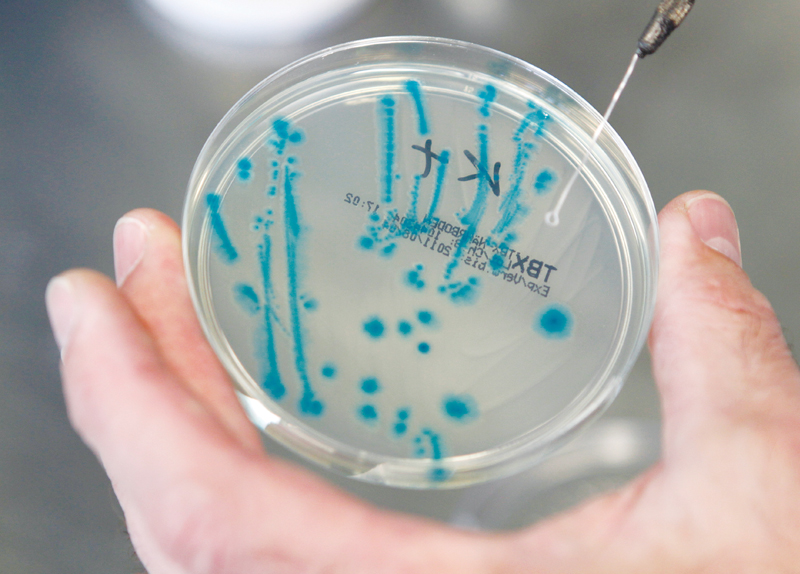

PERSONAL BACTERIA CLOUD
Scientists recently discovered that we all have our own personal cloud of bacteria that we emit around us wherever we are. What’s more, their research found that these clouds actually identify people, just like fingerprints do.
The research team tested these bacterial clouds by placing people in a sealed chamber. Not only were scientists able to detect the specific components in the air around each person, but also identify most of the people individually from the haze emitted around them. “Our results confirm that an occupied space is microbially distinct from an unoccupied one, and demonstrate for the first time that individuals release their own personalized microbial cloud,” the authors of the research concluded.
All humans have these microbes in their intestines and on their skin. We release millions of bacteria in the air and we leave traces of bacteria on everything we touch, like door handles, pens, and elevator buttons. Researchers discovered that the presence of the microbes in the bacteria cloud that could be identified within four hours of someone leaving a sealed chamber. It is the different combinations of bacteria that allow individuals to be distinguished from one another.
Scientists say that these new findings might improve the understanding of how infectious diseases are spread in places, like schools, the subway, or the grocery stores. Furthermore, the research might even indicate a new method for identifying criminal suspects because this method can determine where a person has been from the cloud he or she leaves behind.
VOCABULARY:
identify (신원 등을) 확인하다
fingerprint 지문
sealed 밀폐된
chamber 방
detect 발견하다
specific 특정한
component 요소
haze 실안개
occupied 사용중인
distinct 서로 구분된
demonstrate (증거를 들어가며) 보여주다
personalized 개인 맞춤형의
microbial 미생물의
intestine 장, 창자
trace 흔적
combination 결합
distinguish 구별하다
infectious disease 전염병
indicate 나타내다
criminal suspect 피의자
KOREAN TRANSLATION:
인체 박테리아, 지문처럼 개개인 식별 가능
과학자들은 최근 우리 모두가 어디에 있던지 주변에 내뿜는 자신만의 개인적인 박테리아 구름을 갖고 있다는 것을 발견했다.
게다가, 그들의 연구는 지문들이 그러한 것과 같이, 이러한 구름이 사실상 사람들의 신원을 확인한다는 것을 발견했다.
그 연구 팀은 사람들을 밀폐된 방에 놓고 이러한 박테리아 구름을 시험했다.
과학자들은 각각의 개인 주위에 있는 공기 안에서 특정한 요소들을 발견할 수 있었을 뿐 아니라, 사람들 주위에서 내뿜는 실안개로부터 대부분의 사람들을 개별적으로 확인할 수 있었다.
“우리의 결과들은 사용중인 공간이 미생물적으로 사용중이지 않은 공간과 구별된다는 것을 확인하고, 개인들이 그들 자신의 개인 맞춤형의 미생물의 구름을 방출한다는 것을 처음으로 보여준다,”라고 그 연구의 저자들이 결론내렸다.
모든 사람들은 그들의 장 속과 피부 위에 이러한 미생물들을 갖고 있다.
우리는 공기 중으로 수백만의 박테리아를 방출하고 문 손잡이, 펜, 그리고 엘리베이터 버튼들과 같은, 우리가 접촉하는 모든 것 위에 박테리아의 흔적들을 남긴다.
연구원들은 누군가가 밀폐된 방을 떠난지 4시간 내로 확인될 수 있는 박테리아 구름에 있는 미생물들의 존재를 발견했다.
사람들이 서로 구별되도록 하는 것은 서로 다른 박테리아의 조합들이다.
과학자들은 이러한 새로운 발견들이 어떻게 전염병이 학교, 지하철, 혹은 식료품 가게와 같은 장소에서 퍼지는지에 대한 이해를 향상시킬 수 있다고 말한다.
더욱이, 그 연구는 범죄상의 피의자들을 확인하기 위한 새로운 방법을 나타낼지도 모르는데, 그 이유는 이 방법이 그 또는 그녀가 떠나고 난 뒤에 그 구름으로부터 한 사람이 어디에 있어왔는지를 결정해줄 수 있기 ?문이다